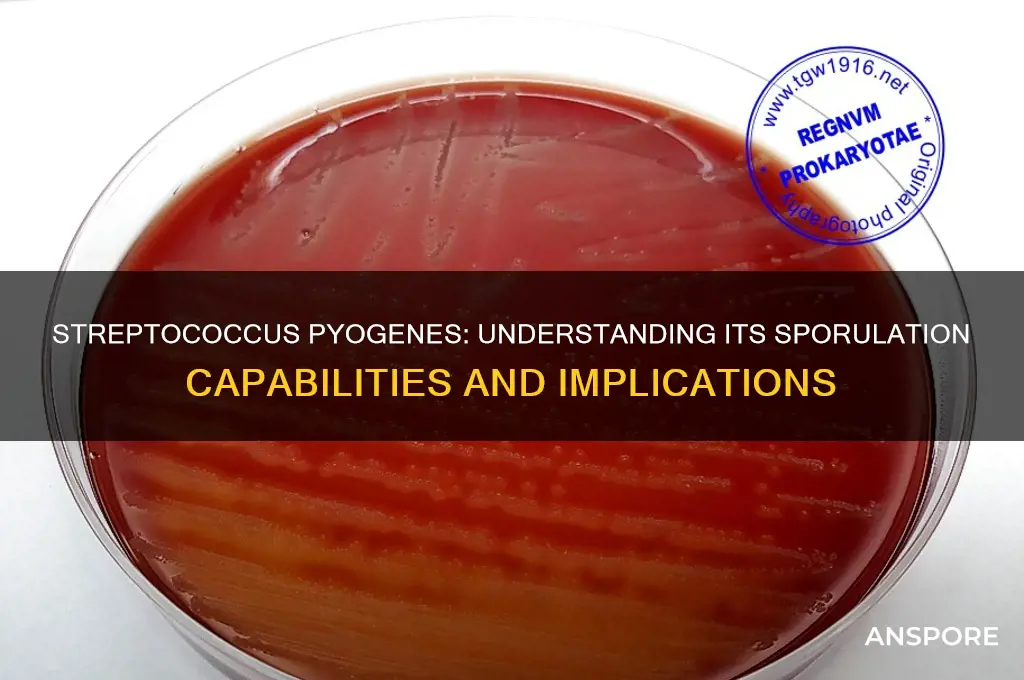
does streptococcus pyogenes form spores

Streptococcus pyogenes, a Gram-positive bacterium responsible for a range of human infections from mild pharyngitis to severe invasive diseases, is known for its ability to thrive in diverse environments within the human body. However, unlike some other bacterial species such as Bacillus and Clostridium, Streptococcus pyogenes does not form spores. Sporulation is a survival mechanism employed by certain bacteria to endure harsh conditions, but S. pyogenes relies instead on its robust metabolic adaptability and virulence factors to persist and cause disease. Understanding its lack of spore formation is crucial for developing effective treatment and prevention strategies against infections caused by this pathogen.
| Characteristics | Values |
|---|---|
| Spore Formation | No |
| Reason | Streptococcus pyogenes is a non-spore-forming bacterium. It lacks the genetic and structural mechanisms required for sporulation. |
| Survival Mechanism | Relies on biofilm formation, persistence in host tissues, and rapid multiplication in favorable conditions. |
| Cell Wall Type | Gram-positive |
| Shape | Cocci (spherical) arranged in chains |
| Optimal Growth Conditions | 37°C, aerobic or facultatively anaerobic, rich medium (e.g., blood agar) |
| Pathogenicity | Causes infections like strep throat, impetigo, cellulitis, and invasive diseases (e.g., necrotizing fasciitis, streptococcal toxic shock syndrome) |
| Antibiotic Susceptibility | Typically susceptible to penicillin, macrolides, and clindamycin, but resistance can emerge |
| Transmission | Respiratory droplets, direct contact with infected skin or mucous membranes |
| Reservoir | Humans (primarily nasopharynx and skin) |
| Genome | Single, circular chromosome; no plasmids typically associated with sporulation |
Explore related products
What You'll Learn

Streptococcus pyogenes spore-forming ability
Streptococcus pyogenes, a Gram-positive bacterium responsible for a range of human infections from strep throat to necrotizing fasciitis, lacks the ability to form spores. This characteristic is a critical distinction from other bacterial species, such as Clostridium difficile or Bacillus anthracis, which survive harsh conditions through sporulation. Spores are highly resistant structures that allow bacteria to endure extreme temperatures, desiccation, and antimicrobial agents, but S. pyogenes relies on other mechanisms for survival outside the host. Understanding this limitation is essential for infection control and treatment strategies, as it highlights the bacterium’s vulnerability to environmental stressors and standard disinfection methods.
Analyzing the biology of S. pyogenes reveals why spore formation is absent in this species. Unlike spore-forming bacteria, which possess genes encoding sporulation proteins and regulatory pathways, S. pyogenes lacks the genetic machinery required for this process. Its survival strategies instead include biofilm formation, which protects it from antibiotics and host defenses, and the production of virulence factors like M proteins and streptolysin O. These adaptations enable it to thrive within the human host but leave it susceptible to external threats once outside its preferred environment. This genetic and physiological difference underscores the importance of targeting S. pyogenes during its active, vegetative state in clinical settings.
From a practical standpoint, the non-spore-forming nature of S. pyogenes simplifies disinfection protocols in healthcare and home environments. Standard cleaning agents, such as alcohol-based sanitizers and bleach solutions, effectively eliminate the bacterium on surfaces. For example, a 70% ethanol solution or a 1:10 dilution of household bleach can inactivate S. pyogenes within minutes. This contrasts with spore-forming bacteria, which often require specialized disinfectants or autoclaving. Patients and healthcare providers can thus rely on routine hygiene practices to prevent transmission, emphasizing handwashing and surface decontamination as key measures.
Comparatively, the inability of S. pyogenes to form spores also influences its treatment and management in clinical infections. Antibiotics like penicillin and amoxicillin remain highly effective against this bacterium, as they target its active growth phase. However, the absence of spores means that recurrent infections are typically due to reinfection or carrier states rather than reactivation from dormant forms. This distinction is crucial for patient education, as it emphasizes the importance of completing antibiotic courses and avoiding contact with carriers during recovery. Unlike infections caused by spore-formers, S. pyogenes cases do not require prolonged environmental decontamination or specialized eradication protocols.
In conclusion, the spore-forming ability is conspicuously absent in Streptococcus pyogenes, a trait that shapes its survival, transmission, and treatment. This limitation, while a vulnerability in harsh environments, simplifies infection control and highlights the bacterium’s reliance on host-associated survival strategies. For healthcare professionals and the public, understanding this characteristic ensures effective prevention and management of S. pyogenes infections, from routine disinfection to targeted antibiotic therapy. By focusing on its active state, we can mitigate its impact without the complexities associated with spore-forming pathogens.
Creating Spore Syringes from Dried Mushrooms: A Comprehensive DIY Guide
You may want to see also

Gram-positive bacteria and sporulation
Streptococcus pyogenes, a notorious Gram-positive bacterium responsible for ailments ranging from strep throat to invasive infections, lacks the ability to form spores. This characteristic distinguishes it from other Gram-positive bacteria like *Clostridium* and *Bacillus*, which are renowned for their sporulation capabilities. Sporulation is a survival mechanism allowing bacteria to endure harsh conditions such as extreme temperatures, desiccation, and antimicrobial exposure. Understanding why *S. pyogenes* does not form spores requires examining the broader context of Gram-positive bacteria and the sporulation process.
Gram-positive bacteria, characterized by their thick peptidoglycan cell wall, exhibit diverse survival strategies. Sporulation, however, is not universal among them. Only specific genera, such as *Bacillus* and *Clostridium*, possess the genetic machinery to form endospores. These spores are metabolically dormant, highly resistant structures that can remain viable for years. In contrast, *S. pyogenes* relies on other mechanisms for survival, such as biofilm formation and rapid adaptation to host environments. This highlights the importance of genetic and environmental factors in determining a bacterium’s survival toolkit.
From an evolutionary standpoint, sporulation is an energy-intensive process, requiring significant resources to synthesize the spore’s protective layers. *S. pyogenes*, as a strict human pathogen, has evolved to thrive in the nutrient-rich environment of the host rather than endure external stresses. Its success lies in its ability to evade the immune system, produce virulence factors, and colonize tissues efficiently. Sporulation, while advantageous for free-living bacteria, would offer little benefit to a pathogen like *S. pyogenes* that depends on continuous host interaction.
Clinically, the absence of sporulation in *S. pyogenes* has practical implications. Unlike spore-forming bacteria, which can survive standard disinfection methods, *S. pyogenes* is more susceptible to environmental stressors. This makes infection control measures, such as hand hygiene and surface disinfection, highly effective against it. However, its ability to cause recurrent infections, such as rheumatic fever, underscores the need for prompt antibiotic treatment. Penicillin remains the drug of choice, with a typical adult dosage of 500 mg every 6 hours for 10 days, though dosage adjustments are necessary for pediatric patients based on weight.
In summary, while sporulation is a remarkable survival strategy for certain Gram-positive bacteria, *S. pyogenes* has evolved alternative mechanisms to ensure its persistence. This distinction not only sheds light on bacterial adaptation but also informs clinical approaches to managing infections caused by this pathogen. Understanding these differences is crucial for both microbiological research and effective patient care.
Do All Homes Harbor Mold Spores? Uncovering the Hidden Truth
You may want to see also

Conditions for bacterial spore formation
Bacterial spore formation is a survival mechanism employed by certain bacteria to endure harsh environmental conditions. Unlike vegetative cells, spores are highly resistant to heat, desiccation, radiation, and chemicals. However, not all bacteria form spores; this ability is primarily observed in specific genera, such as *Bacillus* and *Clostridium*. Streptococcus pyogenes, a Gram-positive coccus responsible for conditions like strep throat and impetigo, does not form spores. Understanding the conditions required for spore formation in other bacteria can shed light on why S. pyogenes lacks this capability.
Spore formation, or sporulation, is triggered by nutrient deprivation, particularly the depletion of carbon and nitrogen sources. For example, *Bacillus subtilis* initiates sporulation when starving in a medium lacking glucose and amino acids. This process is tightly regulated by a complex network of genes, including the master regulator Spo0A. The environment must also be aerobic, as oxygen is required for the synthesis of spore components like the cortex and coat layers. In contrast, S. pyogenes thrives in nutrient-rich environments, such as the human throat and skin, where sporulation is neither necessary nor observed.
The sporulation process involves several distinct phases: vegetative cell growth, asymmetric cell division, engulfment of the smaller cell by the larger one, cortex synthesis, and coat assembly. Each phase is highly coordinated and requires specific environmental cues. For instance, the pH of the medium plays a critical role; *Bacillus* species typically sporulate optimally at a pH range of 7.0 to 8.0. Deviations from this range can inhibit sporulation. S. pyogenes, however, maintains a stable population through rapid binary fission in favorable conditions, eliminating the need for such a complex survival strategy.
Practical considerations for inducing spore formation in laboratory settings include maintaining a controlled environment with precise nutrient limitations and aerobic conditions. Researchers often use defined sporulation media, such as Difco Sporulation Medium, to study this process. For *Bacillus* species, the medium typically contains 8 g/L nutrient broth, 1 g/L KCl, and 1 g/L glucose, adjusted to pH 7.5. Monitoring the process under a phase-contrast microscope allows observation of spore morphology and maturation. S. pyogenes, lacking the genetic machinery for sporulation, remains unaffected by such conditions, further emphasizing its non-sporulating nature.
In summary, bacterial spore formation is a highly specialized process requiring specific environmental triggers, such as nutrient deprivation and aerobic conditions. These conditions are absent in the habitats where S. pyogenes thrives, rendering sporulation unnecessary for its survival. By comparing the sporulation requirements of bacteria like *Bacillus* with the ecological niche of S. pyogenes, it becomes clear why the latter does not form spores. This distinction highlights the diverse survival strategies employed by bacteria in response to their environments.
Optimal Autoclave Spore Testing Frequency for Reliable Sterilization Results
You may want to see also
Explore related products

Streptococcus pyogenes survival mechanisms
Streptococcus pyogenes, the bacterium responsible for strep throat and other infections, does not form spores. This is a critical distinction from spore-forming bacteria like Clostridium difficile, which can survive harsh conditions by entering a dormant state. Instead, S. pyogenes relies on a suite of survival mechanisms to persist in diverse environments, from the human throat to fomites (inanimate objects capable of carrying infection). Understanding these mechanisms is essential for effective infection control and treatment.
One key survival strategy of S. pyogenes is its ability to evade the host immune system. The bacterium produces a capsule composed of hyaluronic acid, which mimics human tissue, allowing it to escape detection by immune cells. Additionally, S. pyogenes secretes proteins like M protein, which inhibits phagocytosis, the process by which immune cells engulf and destroy pathogens. This immune evasion enables the bacterium to establish and maintain infection, even in healthy individuals. For example, in children aged 5–15, who are most susceptible to strep throat, the bacterium’s ability to evade immune responses can lead to recurrent infections if not treated with a full course of antibiotics, typically 10 days of amoxicillin (50 mg/kg/day) or azithromycin (12 mg/kg/day).
Another survival mechanism is S. pyogenes’s adaptability to different environments. It can form biofilms on surfaces, such as medical devices or the epithelial cells of the throat, which protect it from antibiotics and host defenses. Biofilms are structured communities of bacteria encased in a self-produced extracellular matrix, making them up to 1,000 times more resistant to antibiotics than planktonic (free-floating) bacteria. To combat biofilm-associated infections, clinicians often prescribe higher doses of antibiotics, such as 2 g of ceftriaxone daily for severe cases, or recommend mechanical removal of contaminated devices when possible.
S. pyogenes also exploits its ability to colonize multiple niches within the human body. While it is most commonly found in the throat and skin, it can disseminate to other sites, causing invasive infections like necrotizing fasciitis or streptococcal toxic shock syndrome. This versatility is facilitated by virulence factors such as streptokinase, which dissolves blood clots, and streptolysin, which lyses host cells. Preventing such invasive infections requires prompt treatment of superficial infections and vigilance in high-risk populations, such as immunocompromised individuals or those with chronic skin conditions.
Finally, S. pyogenes’s genetic flexibility contributes to its survival. The bacterium can acquire antibiotic resistance genes through horizontal gene transfer, making treatment increasingly challenging. For instance, macrolide resistance in S. pyogenes has risen due to the widespread use of azithromycin, necessitating susceptibility testing before prescribing antibiotics. Public health measures, such as hand hygiene and isolation of infected patients, remain crucial to limit the spread of resistant strains. By understanding these survival mechanisms, healthcare providers can tailor treatments and prevention strategies to effectively combat S. pyogenes infections.
Does Peroxide Effectively Kill Spores? A Comprehensive Scientific Analysis
You may want to see also

Comparison with spore-forming bacteria
Streptococcus pyogenes, the bacterium responsible for strep throat and other infections, does not form spores. This contrasts sharply with spore-forming bacteria like Clostridium difficile and Bacillus anthracis, which produce highly resistant endospores to survive harsh conditions. Understanding this distinction is crucial for effective infection control and treatment strategies.
From a survival perspective, spore-forming bacteria have a distinct advantage. Endospores can withstand extreme temperatures, desiccation, and disinfectants, allowing them to persist in environments where S. pyogenes would quickly perish. For instance, while S. pyogenes dies within minutes on dry surfaces, C. difficile spores can remain viable for months. This resilience necessitates more rigorous disinfection protocols in healthcare settings to prevent outbreaks.
Clinically, the inability of S. pyogenes to form spores simplifies its management. Unlike infections caused by spore-formers, which often require specialized antibiotics like vancomycin or fidaxomicin, S. pyogenes infections are typically treated with penicillin or amoxicillin. However, the rise of antibiotic resistance in S. pyogenes, such as iMLSB resistance, underscores the need for judicious antibiotic use and surveillance.
Practically, this comparison informs infection prevention strategies. For S. pyogenes, standard hygiene measures—handwashing, surface cleaning with alcohol-based disinfectants, and proper waste disposal—are usually sufficient. In contrast, environments contaminated with spore-forming bacteria, such as C. difficile, require sporicidal agents like bleach (1:10 dilution) or hydrogen peroxide wipes. Tailoring these approaches based on bacterial characteristics ensures both efficacy and resource efficiency.
In summary, while S. pyogenes’ lack of spore formation limits its environmental persistence, spore-forming bacteria pose unique challenges due to their resilience. Recognizing these differences allows healthcare providers and individuals to implement targeted measures, from antibiotic selection to disinfection protocols, ultimately improving infection control outcomes.
Do You Need a CD to Play Spore? Here's the Answer
You may want to see also
Frequently asked questions
No, Streptococcus pyogenes does not form spores. It is a non-spore-forming, Gram-positive bacterium.
Streptococcus pyogenes lacks the genetic and metabolic mechanisms required for sporulation, a process typically seen in certain bacteria like Clostridium and Bacillus.
While it does not form spores, Streptococcus pyogenes can survive in certain environments for short periods due to its ability to adhere to surfaces and form biofilms, but it is not as resilient as spore-forming bacteria.
No, none of the streptococcal species, including Streptococcus pyogenes, are known to form spores. Sporulation is not a characteristic of the Streptococcus genus.























![Shirayuri Koji [Aspergillus oryzae] Spores Gluten-Free Vegan - 10g/0.35oz](https://m.media-amazon.com/images/I/61ntibcT8gL._AC_UL320_.jpg)






